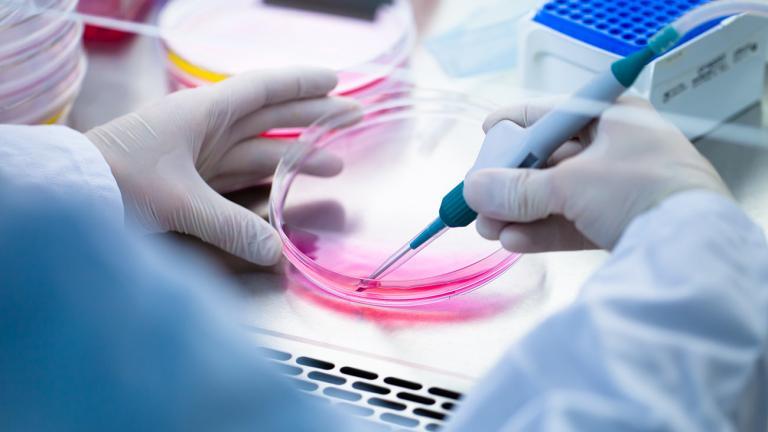
The Axolotl is especially interesting to medical scientists because it keeps its larval tissue its entire life. | PolakPhoto, Shutterstock

This story begins many years ago. The Mexican highlands are still moist and fertile. As millenia pass, they dry out, and become an unfruitful place for salamanders. Eventually, to avoid drying out entirely, the salamanders forgo the typical amphibian transformation process from larvae to salamander, and instead stay in the water forever. To survive, they retain some typical larval attributes throughout adulthood. Because their habitat was restricted to the water, isolating them from other salamander populations, these “eternal infants” developed into an independent species: the Lake Pátzcuaro Salamander.
Neoteny – Maturity in the larval stage









Neoteny – Maturity in the larval stage

The eternal larva
Lake Pátzcuaro Salamanders look like larvae their entire lives. Nevertheless, they are quite big: they can grow to up to 35 centimeters. Two of its remaining larval attributes are particularly striking: the strong, flat tail and the large outer gills. In addition to the gills, however, these salamanders can also breathe through their skin and lungs.
Living at Lake Pátzcuaro








Rich Prey
Lake Pátzcuaro is located at an altitude of 1,920 meters in Michoacán, central Mexico. It has an area of 126 square kilometers – not much, considering this species has no other habitat worldwide. That is why it is especially tragic that the lake is so massively polluted. In addition, tons of the salamanders used to be hunted by fishermen.
The nuns saw the threat to God’s creation – and to the foundation of their lucrative pharmaceutical trade
Wall paintings in the monastery. | Joachim Nerz
In God’s Name
Nuns from the convent came up with the idea of making cough syrup out of the salamanders. Although this sounds bizarre at first, it is probably what saved them from extinction, because the pious nuns noticed that the amphibians were becoming rarer and rarer. The nuns saw the threat to God’s creation – and to the basis of their lucrative cough syrup business. To counteract this threat, they started breeding the salamanders on a large scale in the convent.
Breeding behind monastery walls
It turns out that the nuns were quite talented breeders. While the salamanders are almost completely extinct in the lake, the nuns have managed to breed some specimens in their monastery. Zoos and Citizen Conservation breeders are now also helping conserve this species.

Basic Information on Biology and Breeding
Basic Information on Biology and Breeding
More Species

Almanzor Fire Salamander

Oriental fire-bellied toad
